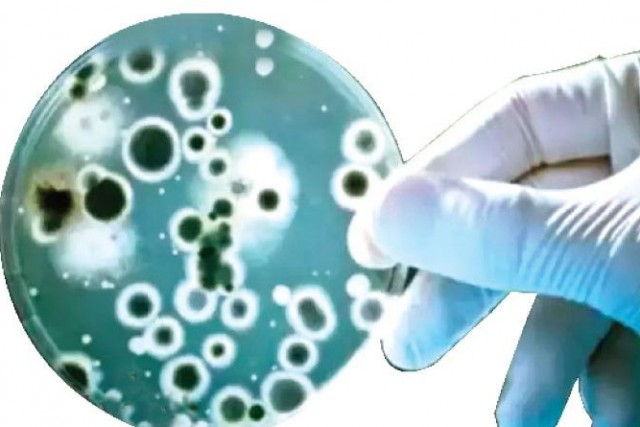
single-page-img

Breaking News
राजस्थान में 31 हजार शिक्षकों की होगी भर्ती, दिवाली से पहले गहलोत सरकार का बडा तोहफा
जयपुर. राजस्थान में बेरोजगारों के लिए बडी खुशखबरी है. राजस्थान सरकार ने 31 हजार तृतीय श्रेणी शिक्षकों की भर्ती को मंजूरी दी है.। रीट परीक्षा होने के बाद इन शिक्षकों की भर्ती की जाएगी. बता दें कि वर्ष 2020-21 के बजट भाषण में कुल 53 हजार पदों की भर्ती की घोषणा राजस्थान के मुख्यमंत्री अशोक गहलोत ने की थी. इनमें से 41 हजार पद शिक्षा विभाग के हैं. शिक्षा विभाग ने 31 हजार तृतीय श्रेणी शिक्षकों की भर्ती के संबंध में प्रस्ताव वित्त विभाग को भेजा था, जिसे मंजूरी दे दी है. इन पदों पर भर्ती से राज्य सरकार पर 2 साल तक परीवीक्षा काल में 881.61 करोड़ और इसके बाद 1717.40 करोड़ रूपये प्रतिवर्ष का वित्तीय भार आयेगा. इतना ही नहीं 282 क्रमोन्नत राजकीय माध्यमिक विद्यालयों में 2489 अस्थाई पदों के सृजन को मंजूरी दे दी गई है. इनमें से प्रधानाध्यापक के 104, वरिष्ठ अध्यापक के 1692, अध्यापक के 411 एवं कनिष्ठ सहायक के...
जॉनसन एंड जॉनसन कंपनी ने अपने कोविड-19 वैक्सीन के मानव परीक्षण को रोका, यह रही वजह
कोरोना वैक्सीन को लेकर बड़ी खबर आई है. जॉनसन एंड जॉनसन कंपनी ने अपने कोविड-19 वैक्सीन के मानव परीक्षण को फिलहाल रोक दिया है. कंपनी का कहना है कि एक वॉलेंटियर में अस्पष्ट बीमारी के कारण परीक्षण को रोकना पड़ा है. कंपनी ने कहा है कि टेस्ट में शामिल हर शख्स की सुरक्षा हमारी पहली जिम्मेदारी है लिहाजा कुछ दिन के लिए ट्रायल रोका जा रहा है.
इस बीच एक्सपर्ट्स वॉलेंटियर की बीमारी को समझने की कोशिश कर रहे हैं. और कंपनी के क्लीनिकल और सुरक्षा से जुड़े डॉक्टर के अलावा स्वतंत्र डेटा मॉनिटरिंग बोर्ड मूल्यांकन कर रहे हैं. उम्मीद की जा रही है की सब कुछ जल्दी ठीक होगा और फिर से इस परीक्षण को शुरू किया जाएगा....
पाकिस्तान ने भी किया चीनी एप Tik Tok को बेन, जानें वजह.
इस्लामाबाद. भारत के बाद पाकिस्तान ने भी टिक-टोक पर बैन लगा दिया है. पाकिस्तान का यह फैसला दुनिया के लिए चौंकाने वाला है. क्योंकि यह एक चीनी ऐप है. पाकिस्तान और चीन के संबंध कितने गहरे और दोस्ताना है यह किस से छुपा नहीं है. ऐसे में भारत के नक्शे कदम पर आगे बढ़ते हुए पाकिस्तान ने चीनी मोबाइल एप टिक टॉक पर बैन लगा दिया है, जाहिर सी बात है की पाकिस्तान ने चीन की नाराजगी की भी परवाह क्यों नहीं की.
पाकिस्तान में Tik Tok पर BAN को लेकर दूरसंचार प्राधिकरण ने कहा कि कंपनी पर अवैध ऑनलाइन सामग्री के सक्रिय मॉडरेशन के लिए एक प्रभावी तंत्र के विकास के निर्देशों का पूरी तरह से पालन करने में विफल रहने का आरोप है. इसलिए टिक टॉक पर पाकिस्तान में प्रतिबंध लगा दिया गया है. ...
इमैनुअल शार्पेंची और जेनफिर डाउडना को मिला केमिस्ट्री के लिए नोबेल पुरस्कार, इतनी बड़ी है इनामी राशि
स्टॉकहोम. केमिस्ट्री विज्ञान में वर्ष 2020 का नोबेल पुरस्कार इमैनुअल शार्पेंची और जेनफिर डाउडना को दिया गया है. यह पुरस्कार जीनोम एडिटिंग का तरीका खोजने के लिए दिया गया है जिसकी स्वीडिश अकेडमी ऑफ साइंसेज पैनल ने घोषणा की है. इस पुरस्कार के जरिए अकसर उन कार्यों को सम्मानित किया जाता है, जिनका आज व्यावहारिक रूप से विस्तृत उपयोग हो रहा है.
पिछले साल की बात करें तो इस कडी में लिथियम-आयन बैटरी बनाने वाले वैज्ञानिकों को नोबेल पुरस्कार से नवाजा गया था. आपको बता दें कि यह पुरस्कार स्वीडन के वैज्ञानिक अल्फ्रेड नोबेल के नाम पर दिया जाता है.
नोबेल पुरस्कार के तहत स्वर्ण पदक के साथ एक करोड़ स्वीडिश क्रोना जो की भारतीय रुपयों में 8.20 करोड़ की राशि है इनाम में दी जाती है. इससे पहले नोबेल पुरस्कार समिति ने शरीर विज्ञान एवं औषधि क्षेत्र का नोबेल पुरस्कार अमेरिकी वैज्ञानिकों- हार्वे जे आल्टर और चार्...
सावधान! अभी 10 माह और रहेगा कोरोना महामारी का खतरा: WHO
जिनेवा. दुनियाभर में कोरोना महामारी का खतरा फिलहाल टला नहीं है. और आने वाले 10 महीनों में भी इसके खत्म होने की संभावना नजर नहीं आ रही हैं. यह बात कोई और नहीं कह रहा बल्कि खुद विश्व स्वास्थ्य संगठन ने कही है. इस लिहाज से अब जरूरत है लोगों को और सावधानी बरतने की, ताकि किसी भी तरह से इस महामारी से निपटा जा सके.
जिनेवा स्थित मुख्यालय में महामारी पर काबू पाए जाने के लिए हो रही बैठक में WHO के हेल्थ इमर्जेंसी प्रोग्राम के कार्यकारी निदेशक माइकल रयान ने यह दावा करते हुए कहा कि, 'अभी आगामी 10 महीने और यह संकट खत्म होने का कोई संकेत नहीं है. कई देशों में कोरोना वायरस नियंत्रण के लिए लगाए गए प्रतिबंधों में ढील के बाद सैकंड वेव आ रही है. इसमें संख्या बढ़ रही है.' माइकल रयान के मुताबिक दुनिया की आबादी में से 10% लोग कोरोनावायरस से संक्रमित हैं. कोरोना वायरस संक्रमण का रिस्क शहरी और ग्रामी...
मेडिसिन के क्षेत्र में नोबेल पुरस्कार की घोषणा, जानें किसे मिला पुरस्कार
स्वीडन के स्टॉकहोम शहर में मेडिसिन के क्षेत्र में नोबेल पुरस्कार की घोषणा कर दी गई है. इस साल का नोबेल पुरस्कार हार्वे अल्टर (Harvey Alter), माइकल हॉफटन (Michael Houghton) और चार्ल्स राइस (Charles Rice) को दिया गया है. इन वैज्ञानिकों को हेपटाइटिस सी वायरस की खोज के लिए दिया गया है. बता दें कि अल्टर और चार्ल्स राइस जहां अमेरिका से हैं वहीं माइकल हॉफटन ब्रिटेन के निवासी हैं. दुनियाभर से तीनों ही वैज्ञानिकों को बधाइयां मिलने का सिलसिला जारी है....
भारत ने परमाणु संपन्न शौर्य मिसाइल का किया सफल परीक्षण, 800 किमी दूर तक टारगेट कर सकता है तबाह
ओडिशा. भारत ने एक और उपलब्धि हासिल करते हुए शनिवार को ओडिशा के बालासोर से शौर्य मिसाइल ने नए वर्जन का सफल परीक्षण किया. जमीन से जमीन पर मार करने वाला यह बैलेस्टिक मिसाइल परमाणु क्षमता से लैस है और 800 किलोमीटर दूर तक टारगेट को तबाह कर सकता है. यह मिसाइल मौजूदा मिसाइल सिस्टम के साथ देश को रक्षा के क्षेत्र में मजबूत करेगा. यह संचालन में हल्का व आसान है. बड़ी बात यह है कि भारत ने इस आधुनिक मिसाइल का परीक्षण ऐसे समय पर किया है जब एलएसी (LAC)पर चीन के साथ तनाव चरम पर है और चीन भारत के हर मामले पर अपनी पैनी नज़र बनाए हुए है.
बता दें कि भारत ने इस बीच ब्रह्मोस सुपरसोनिक क्रूज मिसाइल का भी सफल परीक्षण किया है, जो 400 किमी दूर तक टारगेट को हिट करने में सक्षम है.जो पिछले मिसाइल की क्षमता से 100 किलोमीटर अधिक है.
शौर्य मिसाइल का पहला परीक्षण 2008 में ओडिशा के चांदीपुर समेकित परीक्षण रेंज से किया...
6 साल में कर दिया 26 साल में होने वाला काम, देश के नाम जुड़ी दुनिया की सबसे बड़ी उपलब्धि
हिमाचल. भारत देश के नाम एक और बड़ी उपलब्धि जुड़ गई है. हिमाचल प्रदेश में दुनिया की सबसे लंबी हाईवे सुरंग आमजन के लिए खुल गई है. प्रधानमंत्री नरेंद्र मोदी ने सामरिक रूप से अहम सभी मौसम में खुली रहने वाली अटल सुरंग (अटल टनल) का शनिवार को सुबह 10 बजे हिमाचल प्रदेश के रोहतांग में उद्घाटन किया. बड़ी बात यह है कि इस सुरंग के कारण अब मनाली और लेह के बीच की दूरी 46 किलोमीटर कम हो गई. उद्घाटन के दौरान रक्षा मंत्री राजनाथ सिंह, हिमाचल के CM जयराम ठाकुर भी मौजूद रहे. उद्घाटन समारोह के बाद पीएम मोदी ने लाहौल स्पीति के सीसू और सोलांग घाटी में एक सार्वजनिक कार्यक्रम में संबोधित किया.
अटल सुरंग दुनिया में सबसे लंबी राजमार्ग सुरंग है और 9.02 लंबी सुरंग मनाली को साल भर लाहौल स्पीति घाटी से जोड़े रखेगी. पहले घाटी छह महीने तक भारी बर्फबारी के कारण शेष हिस्से से कटी रहती थी. लेकिन अब ऐसा नहीं होगा. इस टनल स...
लो चीन ले आया अब यह नया वायरस, बुखार के साथ प्रजनन शक्ति कर सकता है खत्म
चीन. दुनिया की आंखों की किरकिरी बना चीन अपनी हरकतों से बाज नहीं आ रहा है. अभी उसकी लापरवाही से कोरोना का कहर दुनियाभर में आतंक मचाए हुए हैं, कोरोना संक्रमण समाप्त होने का नाम भी नहीं ले रहा है कि एक नए वायरस ने चीन में दस्तक दे दी है. इतना ही नहीं इस वायरस से चीन में लोगों में तेज संक्रमित होने का दौर भी शुरू हो गया है. बड़ी बात यह है कि आमतौर पर यह बीमारी मवेशियों को होती है. और यदि यह बीमारी इंसानों को हो जाए तो संक्रमण से तेज सिरदर्द, बुखार और बेचैनी होती है. यह ऐसी बीमारी है जिसकी वजह से पुरुषों और महिलाओं के अंडकोष खराब हो सकते हैं. इसके अलावा यह प्रजनन क्षमता और प्रजनन प्रणाली को पूरी तरह से खत्म कर सकता है.
बता दें चीन के गांसू प्रांत में अब तक 21,847 लोगों की जांच की जा चुकी है. इनमें से 4,646 लोग प्राइमरी तौर पर पॉजिटिव पाए गए हैं. जबकि, 3245 लोग स्पष्ट तौर पर इस बीमारी से संक्...
देसी वैक्सीन का पहले ही चरण में कमाल, बंदरों में किया कोरोना वायरस का सफाया
नई दिल्ली. भले ही भारत में दुनिया के अन्य देशों के साथ सीरम इंस्टिट्यूट की ऑक्सफर्ड वैक्सीन का ट्रायल रोक दिया गया हो लेकिन कोरोना की जंग में अच्छी खबरें आने का सिलसिला अभी भी जारी है. देश के वैज्ञानिक और चिकित्सक कोरोना संकटकाल का मुकाबला करने के लिए दिन रात एक किए हुए हैं.
BIG NEWS: भारत में 64 लाख लोग मई में ही हो चुके थे कोरोना संक्रमित! पूरी खबर पढें.
अब जो बड़ी और अच्छी खबर आई है वो यह है कि भारत बायोटेक की कोरोना वायरस वैक्सीन 'कोवैक्सिन' का जानवरों पर ट्रायल सफल रहा है. खुद कंपनी ने इसकी घोषणा करते हुए बताया कि Covaxin ने बंदरों में वायरस के प्रति ऐंटीबॉडीज विकसित की, जो अच्छे संकेत हैं. कुल मिलाकर यह कहा जा सकता है कि लैब के अलावा जीवित शरीर में भी यह वैक्सीन कारगर साबित हुआ है.
भारत बायोटेक ने इसके लिए पहले चरण में खास तरह के बंदरों को वैक्...